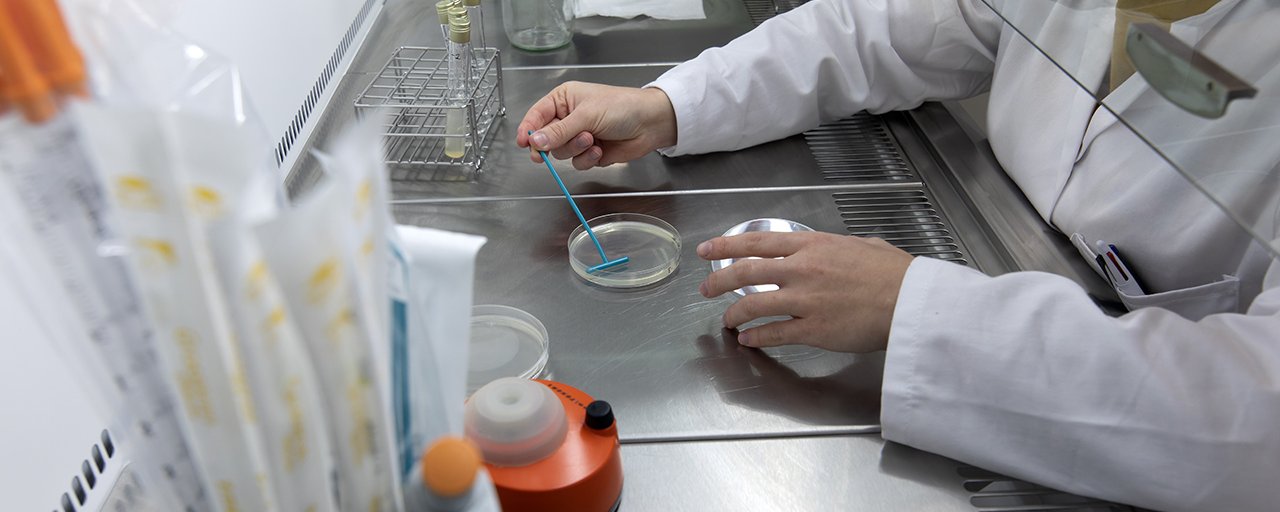

Les + NBCO SOLUTIONS
- Une approche globale de votre station : audit, diagnostic, traitement, suivi et assistance technique.
- Des compétences croisées à votre service : microbiologie, chimie, mesure physique, méthanisation.
- Des expériences complémentaires, issues des industries papetières, agroalimentaires et chimiques.
- Des activités intégrées : analyses de données, laboratoire, production des nutriments, NBCO SOLUTIONS est indépendante pour toutes ses prestations : qualité, maîtrise des process, savoir-faire technique et réactivité garantis.
Les + NBCO SOLUTIONS
- Une approche globale de votre station : audit, diagnostic, traitement, suivi et assistance technique.
- Des compétences croisées à votre service : microbiologie, chimie, mesure physique, méthanisation.
- Des expériences complémentaires, issues des industries papetières, agroalimentaires et chimiques.
- Des activités intégrées : analyses de données, laboratoire, production des nutriments, NBCO SOLUTIONS est indépendante pour toutes ses prestations : qualité, maîtrise des process, savoir-faire technique et réactivité garantis.